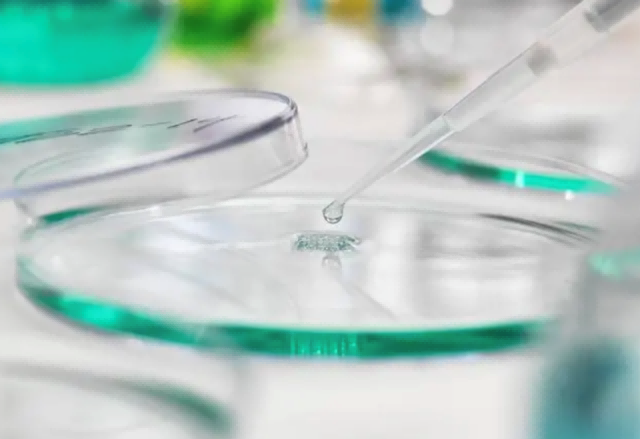
微信图片_2026-01-19_091330_508 微信图片_2026-01-19_091330_508

中鼎设计微信服务号

天下事,在局外呐喊议论,总是无益,必须躬身入局,挺膺负责,方有成事之可冀。
张盛英说关键的是把自己变成解决问题的关键。
32年行业经验,张盛英是四库专家:四川省评标专家、四川省建设厅专家库成员、四川省财政厅评标专家、中华人民共和国财政部评标专家;拥有6项注册工程师认证:注册公用设备(给水排水)工程师、注册造价工程师(土建、安装)、注册监理工程师(土木、水利)、一级注册建造师(机电)、注册咨询(投资)工程师、注册设备监理师;高级工程师(给排水、环境保护、市政三专业)。
张盛英的职业生涯有一个词始终伴随着她:躬身入局。

张盛英
- 四库专家
高级工程师(给排水、环境保护、市政)
一级注册建造师(机电)、注册公用设备工程师(给排水)
注册造价工程师(土建、安装)、注册监理工程师(土木、水利)
注册咨询工程师(投资)、注册设备监理师
- 曾就职于成都康弘药业、中国电子工程设计院(原电子十院)
- 成都科技大学(现四川大学)学士
拥有 32 年行业经验
业务覆盖医药、工业、市政等领域
多专业、多阶段,熟知项目的全过程
是行业里的全能型专家
- 代表项目:成都双子塔灯光秀工程项目
成都英特尔项目、成都京东方项目、康弘药业等


▲张盛英代表作——成都双子塔灯光秀工程/图源网络
该项目位于高新区交子大道,包含东起金融中心双塔,西至成汉南路两侧夜景提升工程,分为金融城双子塔灯光演绎秀及建筑景观秀、交子大道两侧建筑媒体灯光秀、城市景观花海、街区音效系统、LED屏微电影系统、智能化总控及机房等系统。涵盖了金融城双子塔、华商景观照明、中海景观照明、悠方景观照明、道路景观照明和交子大道建筑外立面光彩照明等。

▲张盛英代表作——英特尔成都公司(图片来源于网络)
该项目是英特尔公司在成都市半导体封装测试项目投建的第二阶段,该项目投资3.5亿美元,是当时成都市的重点项目之一。

▲张盛英代表作——成都京东方公司/图源网络
该项目是当年成都投资最大的项目之一,是京东方在京外投产的第一条4.5代液晶显示器生产线建设项目。
01
主动选择机遇
时间回到36年前,1988年
当时张盛英被第一志愿成都科技大学(现四川大学)录取,就读于该学院的水利土木系。
提及为什么选择这个专业,她说这离不开塑造她的土地,张盛英成长在那个时代背景下普通的农民家庭,扎根、务实羁绊这时年仅20岁的她,当时行业的大热专业第一是计算机,第二就是工程相关的专业,那个时候对于她来说计算机几乎是未知的,而脚下的水利土木是更亲切的更熟悉的存在。
在学校第二年完分专业时张盛英选择了她更喜欢的给排水专业,命运的篇章也开始徐徐展开。历史滚滚向前,也推动着踩在篇章上的每一个人。


▲张盛英在成都科技大学时的照片©张盛英
1992年张盛英大学毕业,迎来了她的第一份工作:四川长征制药厂设计室(现四川长征工程设计院)给排水专业技术员,因为一些偶然的原因张盛英争取到了公司外派进行中级预算员脱产半年的学习,这次学习促成了她在项目估概算的专业能力,也为后来的职位发展奠定了机会。半年的学习使张盛英从最开始单一的给排水工程师视角拉到了更宏观的整体项目视角,学习归来后工作也从以前的给排水专业设计扩展至项目的投资估算及经济分析、设计概算以及施工图预算相关工作实践。

▲长征工程设计院/图源网络
1998年,当时为了在项目概预算上有更深的专业能力更多的发展可能,张盛英参加当年的注册造价师的执业资格考试,也是因为这次考试而带来的机缘,让她进入了当时的成都康弘制药有限限公司(现成都康弘药业集团股份有限公司)。

▲康弘药业©张盛英
当时才进入康弘不久就迎来了张盛英职业生涯的又一次重大考验,当时康弘制药正在开展GMP认证相关的准备。1999年6月国家药品监督管理局颁发了《药品生产质量管理规范(1998年修订)》,明确未取得药品GMP认证证书的企业,卫生部不予受理生产新药的申请;对未取得药品GMP认证证书的,不得发给《药品生产企业许可证》。因此整个集团都在为该认证全力以赴开展工作,张盛英需要全面对企业的水系统进行升级,保障企业的医药用水(纯化水和注射用水)每个环节。

▲纯水处理工艺图

▲药厂给排水©张盛英

▲康弘制药注册类药品/图源网络
经过大家的共同努力,最终企业拿到第一批药企的GMP认证(取得了国家药品监督管理局成立以来核发的第一张药品GMP认证证书(证书编号:A0001))。而后康弘制药在多地的新办厂区的水系统都是张盛英参与建成,因此渐渐累计大量从项目立项(可研)-设计(报规、初设及施工图设计)-报建及建造-试运行-项目移交的交钥匙工程的全过程项目管理经验。但也是同时期因为长期不稳定的工作地点让她与家人长期分离,而这时命运之手又缓缓向她伸出手去。

▲成都康弘制药有限公司GMP证书/图源网络
02
每一次都先前进

▲中国电子工程设计院©中国电子工程设计院有限公司官网

▲张盛英在电子工程设计院时的照片©张盛英
2003年,张盛英因为她独特的专业能力让她有机会进入了中国电子工程设计院(原电子十院),契机是当时有一项保密项目需要专业的可研经济分析人才,而当时具备有项目经济分析能力的人才很少,一是大多数人才不具备相关的数据能力,二是有投资估算能力的大多没有实际设计阶段经验,无法使得两个环节的紧密衔接,而这个项目要求较高,因此电子十院向她抛出了橄榄枝。最后张盛英也不负所望顺利得完成了该项目工作。
提及当时为什么选择进入电子十院,张盛英说除了一些外部原因,其实最重要的还是专业的追求,作为给排水专业的行业从业者,心理一直有一个期待,电子及航空领域对水的纯度(电阻率)要求是最高的,有时接近水的理论电阻“18.3MΩ.cm”,想到这个行业去学习学习,水如何处理才能达到这个极值以及如可运行维护管理,带着这样的期待张盛英开启了她在电子十院八年多的职业生涯。
▲图片来源于网络
时间来到2008年。
当时张盛英和团队合计共60多人正在合力攻破当时成都投资最大的项目:京东方项目的设计工作。
同年5.12特大地震使每个中国人都陷入了沉痛之中,看到震后的城市和人民,张盛英非常希望能贡献出自己的一份力量为灾后建设出力,因此在接到国防科工委邀请,她义不容辞,以给排水和经济专家身份,与国家发改委和国防科工委的相关领导及其他专家一起参与到对川内电科系统(四大军工研究所)的灾后应急恢复生产的现场踏勘与评估工作,领导和专家小组一起前往四大所的相关各地(成都、眉山、彭州、绵阳)对损失进行了及时的专业的评估,为科工委应急拨款提供了直接依据,为灾后应急恢复生产提供有力支持。

▲成都京东方光电科技有限公司/图源网络
京东方成都4.5代TFT-LCD生产线项目,主要生产12.1英寸以下的笔记本电脑、平板电脑、数码相框、车载显示、移动显示、手机等用中小尺寸显示面板,是当时我国西部地区首条实现量产的液晶面板生产线,也是当时国内唯一实现彩色滤光片和液晶面板集成化生产的全自动化生产线。

▲成都英特尔当时的项目新闻/图源网络

▲成都英特尔芯片制作中心/图源网络
2005年,英特尔公司将在成都投建半导体封装测试项目的第二阶段工程。当时张盛英与项目团队30多人在上海外滩中心共同完成该项目的概念设计,以及该项目后续在成都完成的初步设计和施工图设计工作。
03
工程师不能自我设限
经过大院的沉淀磨砺后,张盛英期待自己有新的突破,因此离开了电子十院。
新的章程被展开,2012年~2018年张盛英在此期间通过了全国注册咨询工程师(投资)考试,取得执业资格,同时参加了国际标准ISO9000、ISO14000、OHSMS18000和GB/T50430的系统培训,并通过了注册考试,取得国家注册审核员资格,兼职参与审核了不同行业的各种类型的企业和组织,对国际标准进行了很好的把握。同时在此阶段,张盛英全面的参与了项目的招投标阶段的工作,因此整个行业链条在她这里完成了闭环。
2019年张盛英作为交子大道夜景提升一期工程的总监,为成都金融城双子塔的灯光秀工程提供专业技术服务(金融城双塔外立面LED金属条形屏安装。北塔58层,为公寓及配套服务商业;南塔48层,为办公及商务会议功能,建筑高度均为220m;根据图纸施工要求,双塔设置定制化LED金属灯条屏。南北双塔灯条铺设面积共为52000㎡),保障了项目的如期保值交付,该项目又是时间紧、政治任务重、责任重大的工程。
回顾张盛英之前的职业生涯,她总是能在这样的条件下开展工程工作,且每次都能保值甚至是超值完成。谈到是什么带给她这样的力量,张盛英说机会总是留给有准备的人,我时刻准备着。

▲成都双子塔灯光秀/图源网络
04
访谈问答
Q1是什么激励着您,在职业生涯中一直保持高效学习,拿到了六个注册工程师职称?
在我看来工程行业是应用型行业,除非部分专精研发类从业人员需要不断精研,大多数的工程人员最好的发展就是让自己成为全能型的人才。工程项目每个板块不是独立存在的,它实际是一个嵌合度极高的整体,你需要了解到各个板块中的专业逻辑、运营规则才能更好管理项目,考证实际是训练自己对各版块应用的及时调动能力,保障在每个项目的推进时我都有良好的掌握感。
Q2您能跟我们分享一下,您在这么多年职业生涯中有那些转折让您影响深刻?
印象深刻的是比较多的,但比较意外具有戏剧性的还是我从四川长征工程设计院到成都康弘药业集团的经历。1998年我在准备当时注册造价师考试,因为考试前的集中培训,结识了当时一起考试的另一位学员,因为她当时有计划希望换工作,所以就陪她一起去四川人才中心做人才档案存档,后来就是我被成都康弘药业在人才中心选中,而陪我一起当时的同学她却没有换工作成功。到了康弘后我记得很清楚当时因为实习表现非常好,转正后的工资是定在3000,而原来在四川长征工作设计院时工资是200,涨幅了二十五倍。现在回想起来如果没有当时在长征的半年中级预算员脱产学习,没有当时报考注册造价师也就不会有后来的机会。
Q3您经历了很多时间紧、任务重、责任重大的项目,这些项目里那些时刻让您印象最为深刻,您能为我们分享一些当时的细节吗?
5.12大地震后作为专家组成员,参与对川内电科系统四大军工研究所的给排水专业的设施设备的灾后损失专业评估,当时情况是非常紧张的,当时地震造成了唐家山堰塞湖,而当时堰塞湖的抢险情况还不明朗,但我们又必须前往位于唐家河堰塞湖的下游绵阳,对电子科技第九研究所恢复生产进行第一步工作,第九所担任着神州5号航天任务中某些生产任务,应急恢复生产工作刻不容缓。当时我们专家组成员每个人的那根弦都是紧绷着,我们到达现场后,第一时间就是前往现场进行勘察对相关情况做出专业的评估,并于当天完成评估报告,应急小组的领导也是第一时间就把报告提供给了科工委,为科工委应急拨款提供了及时依据。
在近一点,是当时在负责成都金融城双子塔的灯光秀工程时,我几乎每天都和建设单位、施工单位的管理人员一起从早到晚都蹲在双子塔下面,紧盯着挂在双子塔外立面的上作业人员(业主配置了望远镜、对讲机等),有任何违规操作立马纠正整改或下达停工令。整个项目工期是非常紧张的,而且建筑结构原因,外立面的灯条需要工人们悬吊着一段一段的安装,对整个项目安全的管控必须是极致的。当项目完成后,成都双子塔的光芒在成都人民的朋友圈刷屏的时刻让我非常澎湃,那种收获感成就感是无与伦比的,这也是工程对于工程师的魅力所在。
Q4您有什么建议给到现在的行业青年工程师们吗?
中国城镇化率到了尾声,但城镇化建设还远远不止,新时代会有新时代的风貌。最重要的还是要有那份热爱,不要停止追求自己的卓越。
05
全过程咨询

▲张盛英全过程咨询项目案例——云供养研发生产基地
该项目生产基地用地39.44亩,其中规划建筑总面积约2800平方米,计划总投资5.1亿元,主要建设国内独一无二的云供氧平台。

▲张盛英全过程咨询项目案例——昇锐制药项目
该项目生产基地占地45.05亩,一期建筑面积约17000平米,该项目荣获2022年度眉山市“平安工地”示范工程荣誉称号。



▲张盛英全过程咨询项目案例(某医学类项目)